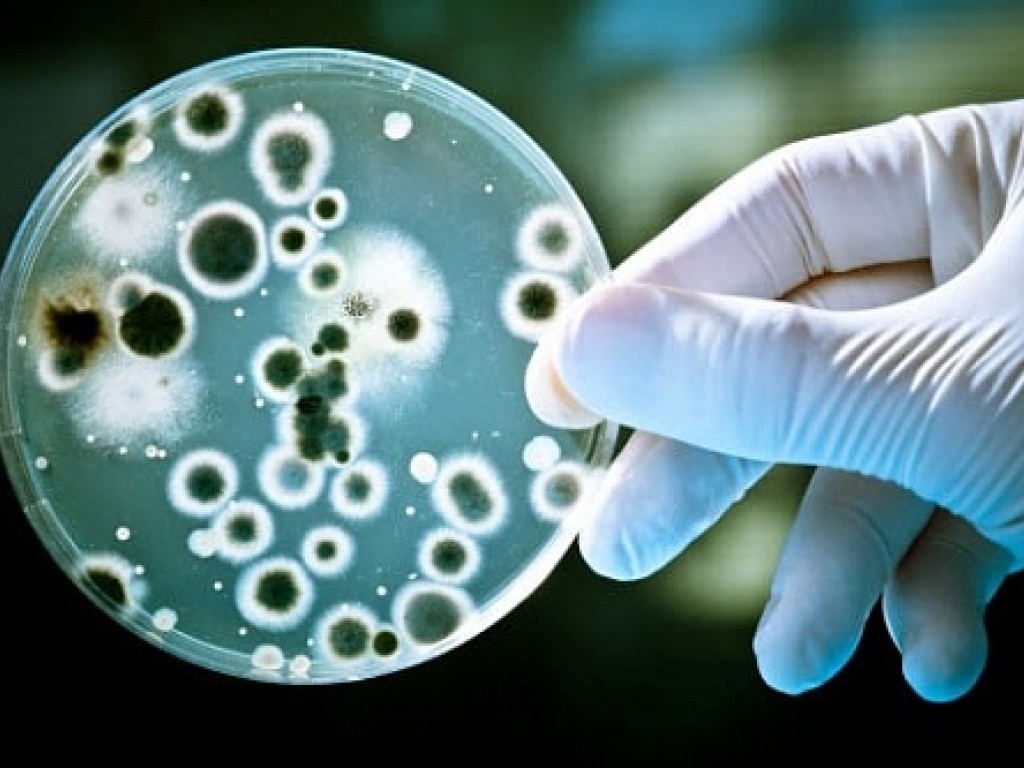

Кишечная палочка обнаружена в сэндвичах в Караганде
Департамент охраны общественного здоровья Карагандинской области провел экспертизу пищевой продукции в регионе. За пять месяцев года на объектах торговли показали несоответствие в 14 процентов исследованных образцов продукции, передает корреспондент МИА «Казинформ».
«По результатам экспертизы выявлена несоответствующая продукция производства ИП Базылбеков М.Г. В трех пробах сэндвичей, отобранных на разных объектах торговли, обнаружена кишечная палочка и превышение общей микробной обсемененности. При проведении мероприятий установлено, что по указанному адресу ИП Базылбеков М.Г отсутствует, а вместе с тем, в соответствии с действующим законодательством не уведомил территориальное управление охраны общественного здоровья о начале своей деятельности.
Материалы по данному факту направлены в УВД города Караганды»,- сообщили в пресс-службе департамента охраны общественного здоровья области. Департаментом проводились исследования на соответствие требованиям технических регламентов и гигиенических нормативов как продукции отечественного производства так и ввозимой с других стран. Как сообщили в ведомстве, основная доля несоответствующей пищевой продукции приходится на мясную - 32,9%, птицепродукцию - 16,8%, на рыбную -14,9%, молочную продукцию - 12,2%, на кондитерские изделия приходится 6,8%, мукомольные изделия - 3%, кулинарные изделия - 3,4%, масложировую продукцию - 2,2%, и 7,8% приходится на прочую продукцию.
Стоит отметить, что из общего количества несоответствующей пищевой продукции в 16,5% случаях продукция не соответствовала по бактериологическим показателям безопасности, в 8,4% выявлены несоответствия по физико-химическим показателям, 73,9% несоответствий приходится на маркировку, и в 1,5% выявлены нарушения в части обмана потребителей (несоответствие по жирно-кислотному составу молочной продукции и обнаружение ДНК свинины, не заявленной производителем). Кроме того, в рамках мониторинга выявлена опасная продукция производителя, который фактически отсутствует по заявленному адресу. В результате проведенных мероприятий за 5 месяцев года снято с реализации 5432 кг пищевой продукции. Субъектам предпринимательства вручено 87 предписаний, их них проведена проверка 69. Вынесено 8 постановлений специализированного административного суда на общую сумму 1418950 тенге, наложено 6 штрафов на сумму 329485 тенге.
Источник: КАЗИНФОРМ

